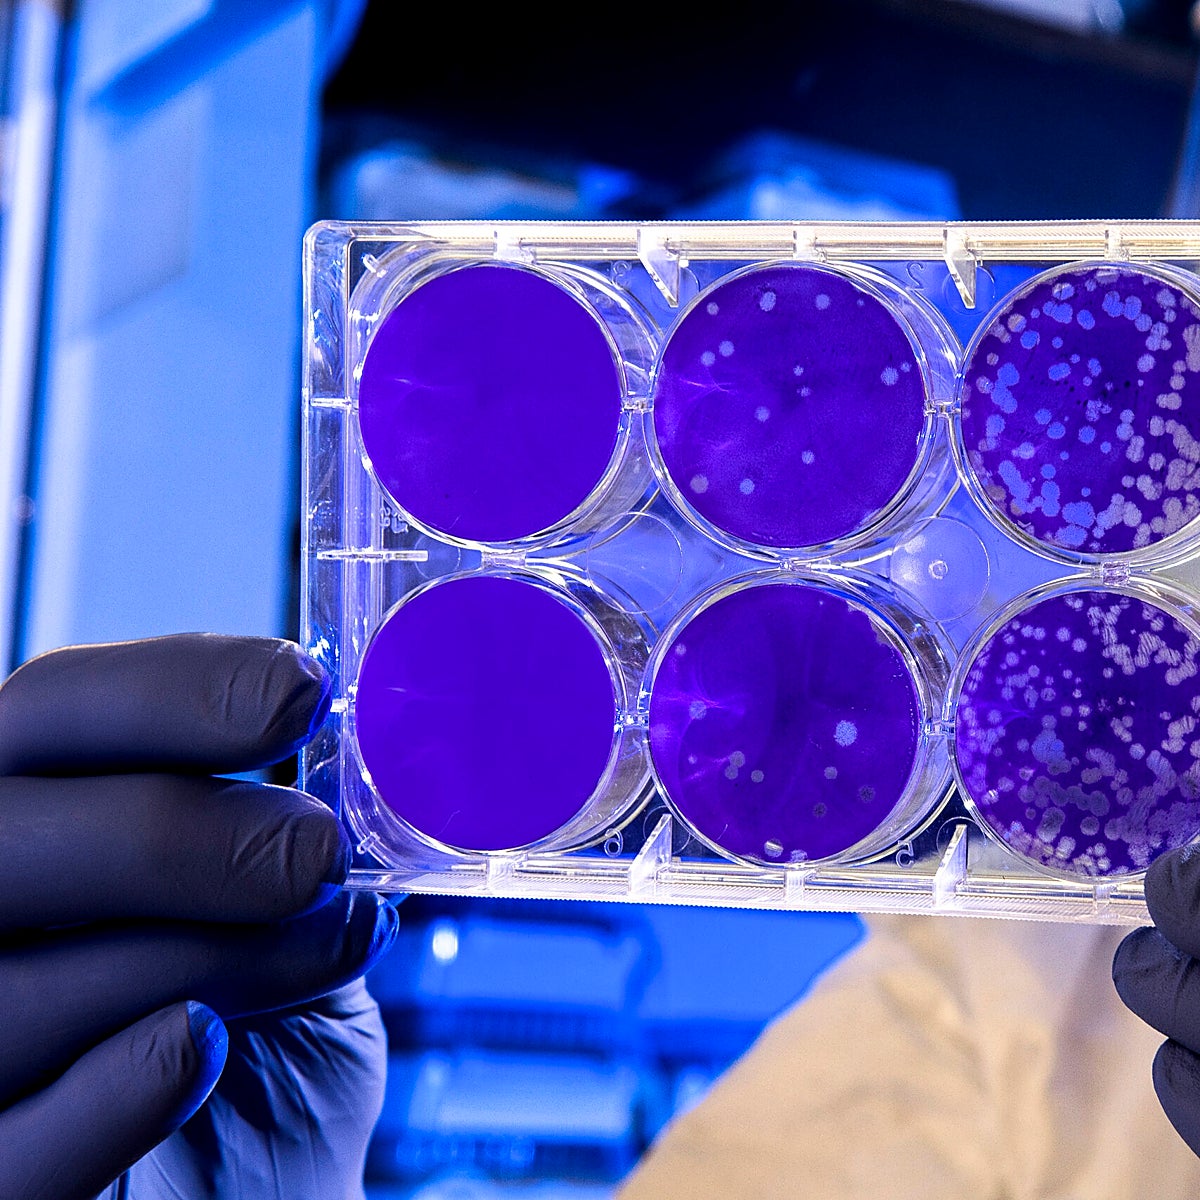
Un nuevo marcador genómico facilita la terapia dirigida para un tipo de cancer colorrectal metastásico

Josep Tabernero, el Hospital Clínico y la protonterapia de QuironSalud, premios ABC Salud
Los avances en diagnóstico y tratamiento del cáncer, reproducción humana y enfermedades cardiovasculares centran la duodécima edición de los galardones
Tras dos ediciones centradas en la pandemia, los avances en Oncología han protagonizado la última edición de los premios ABC Salud. El jurado, presidido por Ana Pastor, vicepresidenta segunda del Congreso y exministra de Sanidad, ha reconocido la innovación de proyectos que mejoran el ... diagnóstico y tratamiento, así como la labor clínica e investigadora del oncólogo catalán Josep Tabernero. Pero también el fármaco que protege el corazón, avances en reproducción y estrategias contra el Covid en las ocho categorías que distinguen estos galardones.
Como en años anteriores, ABC Salud ha contado con un jurado de excepción. Además de Pastor, han formado parte: el exviceconsejero de Sanidad de Madrid, Antonio Zapatero; la directora de la ONT, Beatriz Domínguez; el director del Instituto de Salud Carlos III, Cristóbal Belda; Federico de Montalvo, vicerrector de la Universidad Pontificia de Comillas, María Blasco, directora del CNIO y Nuria Ramírez de Castro, redactora jefe de Sociedad. Estos son los galardones:
Médico del año: El oncólogo Josep Tabernero
Director del Instituto de Oncología del Hospital Vall d'Hebron en Barcelona, Josep Tabernero es un referente internacional en la investigación del cáncer colorrectal y los tumores digestivos. Su investigación, aplicada a la clínica, ha cambiado el tratamiento de los pacientes con el diseño de terapias dirigidas más eficaces, en lo que se denomina oncología de precisión. Expresidente de la Sociedad Europea de Oncología Médica, también ha contribuido a la aprobación de más de 40 fármacos oncológicos.
-
La polipíldora, la 'pastilla del corazón', reduce la mortalidad en un 33% tras un infarto
Nuria Ramírez de Castro
Hospital público: Clínico San Carlos por su unidad de Inmunología reproductiva
El hospital madrileño puso en marcha en 2018 una unidad funcional de Inmunología Reproductiva, pionera en la sanidad española. Dedicada al diagnóstico, tratamiento y seguimiento gestacional de parejas con abortos espontáneos recurrentes o fallos de implantación tras tratamientos de fertilidad han conseguido una tasa de éxito gestacional del 94%. Silvia Sánchez-Ramón está al frente de esta unidad pionera en la que se combina la investigación con la clínica.
Hospital privado: Centro de Protonterapia Quirón Madrid
La sanidad privada ha sido pionera en poner en marcha los primeros centros de protonterapia, la radioterapia más precisa contra el cáncer. Menos lesiva y eficaz, permite atacar el tumor reduciendo el riesgo de dañar tejidos sanos en comparación con las técnicas de radioterapia convencional que utilizan fotones o electrones. El centro de protonterapia Quirónsalud de Pozuelo (Madrid) fue el primero en construirse en España. Desde allí atiende a pacientes de todo el país, en colaboración con la sanidad pública.
Mejor medicamento: La polipíldora que protege el corazón
El cardiólogo Valentín Fuster tuvo una idea feliz: ¿por qué no combinar en una sola pastilla los tres fármacos que se recetan tras un infarto? Así se simplificaba la toma y se luchaba contra los olvidos de los enfermos. Esa idea se materializó en una polipíldora que desarrolló el Centro Nacional de Investigaciones Cardiovasculares (CNIC) con el laboratorio Ferrer. El fármaco, no es solo una opción más cómoda también es más efectiva porque reduce en un 33% la mortalidad tras un infarto.

Tecnología sanitaria: IA para diagnosticar el cáncer
La inteligencia artificial se ha convertido en el mejor aliado del diagnóstico del cáncer. El sistema de Fujifilm afina el diagnóstico de cada paciente. Lo hace en equipos de endoscopia para el cribado del cáncer de colon y es capaz de generar una predicción sobre los pólipos sospechosos de malignizar. En mama también hacen más fácil identificar lesiones que podrían ser difíciles de visualizar en la mamografía tradicional.
Enfermería: 'Maternity Blues'
Este programa de enfermería del Hospital Sanitas La Zarzuela ha permitido contar con una unidad de apoyo emocional para las mujeres que sufren depresión o disforia postparto, cuyo trastorno suele pasar desapercibido.
Farmacia: Entrega de test en Madrid
Las farmacias de Madrid entre diciembre de 2021 y marzo de 2022 dispensaron de forma gratuita más de 4,6 millones de test de antígenos de autodiagnóstico de covid-19 para frenar la expansión de la infección en un momento de incremento de la incidencia. Los farmacéuticos madrileños contribuyeron de forma activa y desinteresada al control de la pandemia.
Mejor fundación, Mundo Sano
La fundación Mundo Sano trabaja desde 1993 por las víctimas de enfermedades que han quedado desatendidas por el resto del mundo y que padecen 1.600 millones de personas. Chagas, dengue, zika o leishmaniasis, entre otras infecciones que están expandiéndose en un mundo global. Mundo Sano ha trabajado especialmente para que muchas personas tengan acceso al tratamiento de la enfermedad de Chagas.
Esta funcionalidad es sólo para suscriptores
Suscribete
Esta funcionalidad es sólo para registrados
Iniciar sesiónEsta funcionalidad es sólo para suscriptores
Suscribete